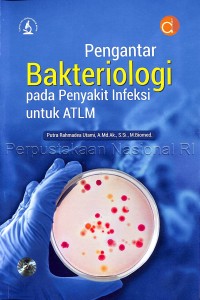
pengantar bakteriologi pada penyakit infeksi untuk ATLM

Text
pengantar bakteriologi pada penyakit infeksi untuk ATLM
Bakteriologi adalah salah satu cabang ilmu yang mempelajari bakteri. Prosedur pemeriksaan bakteriologi meliputi isolasi bakteri dari sampel, penanaman pada media pertumbuhan yang sesuai, identifikasi bakteri berdasarkan karakteristik morfologi, pewarnaan Gram, dan tes biokimia. Pemeriksaan bakteriologi sering digunakan dalam pengujian laboratorium untuk memastikan keamanan makanan dan air minum, serta dalam penelitian ilmiah untuk mempelajari sifat dan karakteristik bakteri. Buku ini membahas tentang rupa-rupa bakteri yang banyak ditemui, juga jenis-jenis infeksi yang disebabkan oleh patologis bakteri tersebut, dan langkah-langkah pencegahannya.
Ketersediaan
| 1904901 | 616.920 1 PUT p | Tersedia - Indonesia |
Informasi Detail
- Judul Seri
-
-
- No. Panggil
-
616.920 1 PUT p
- Penerbit
- Yogyakarta : deepublish., 2022
- Deskripsi Fisik
-
viii, 167 halaman : ilustrasi ; 23cm
- Bahasa
-
Indonesia
- ISBN/ISSN
-
978-623-02-5549-6
- Klasifikasi
-
616.920 1
- Tipe Isi
-
-
- Tipe Media
-
-
- Tipe Pembawa
-
-
- Edisi
-
Cetakan pertama, November 2022
- Subjek
- Info Detail Spesifik
-
-
- Pernyataan Tanggungjawab
-
-
Versi lain/terkait
Tidak tersedia versi lain
Lampiran Berkas
Komentar
Anda harus masuk sebelum memberikan komentar




























 Karya Umum
Karya Umum  Filsafat
Filsafat  Agama
Agama  Ilmu-ilmu Sosial
Ilmu-ilmu Sosial  Bahasa
Bahasa  Ilmu-ilmu Murni
Ilmu-ilmu Murni  Ilmu-ilmu Terapan
Ilmu-ilmu Terapan  Kesenian, Hiburan, dan Olahraga
Kesenian, Hiburan, dan Olahraga  Kesusastraan
Kesusastraan  Geografi dan Sejarah
Geografi dan Sejarah